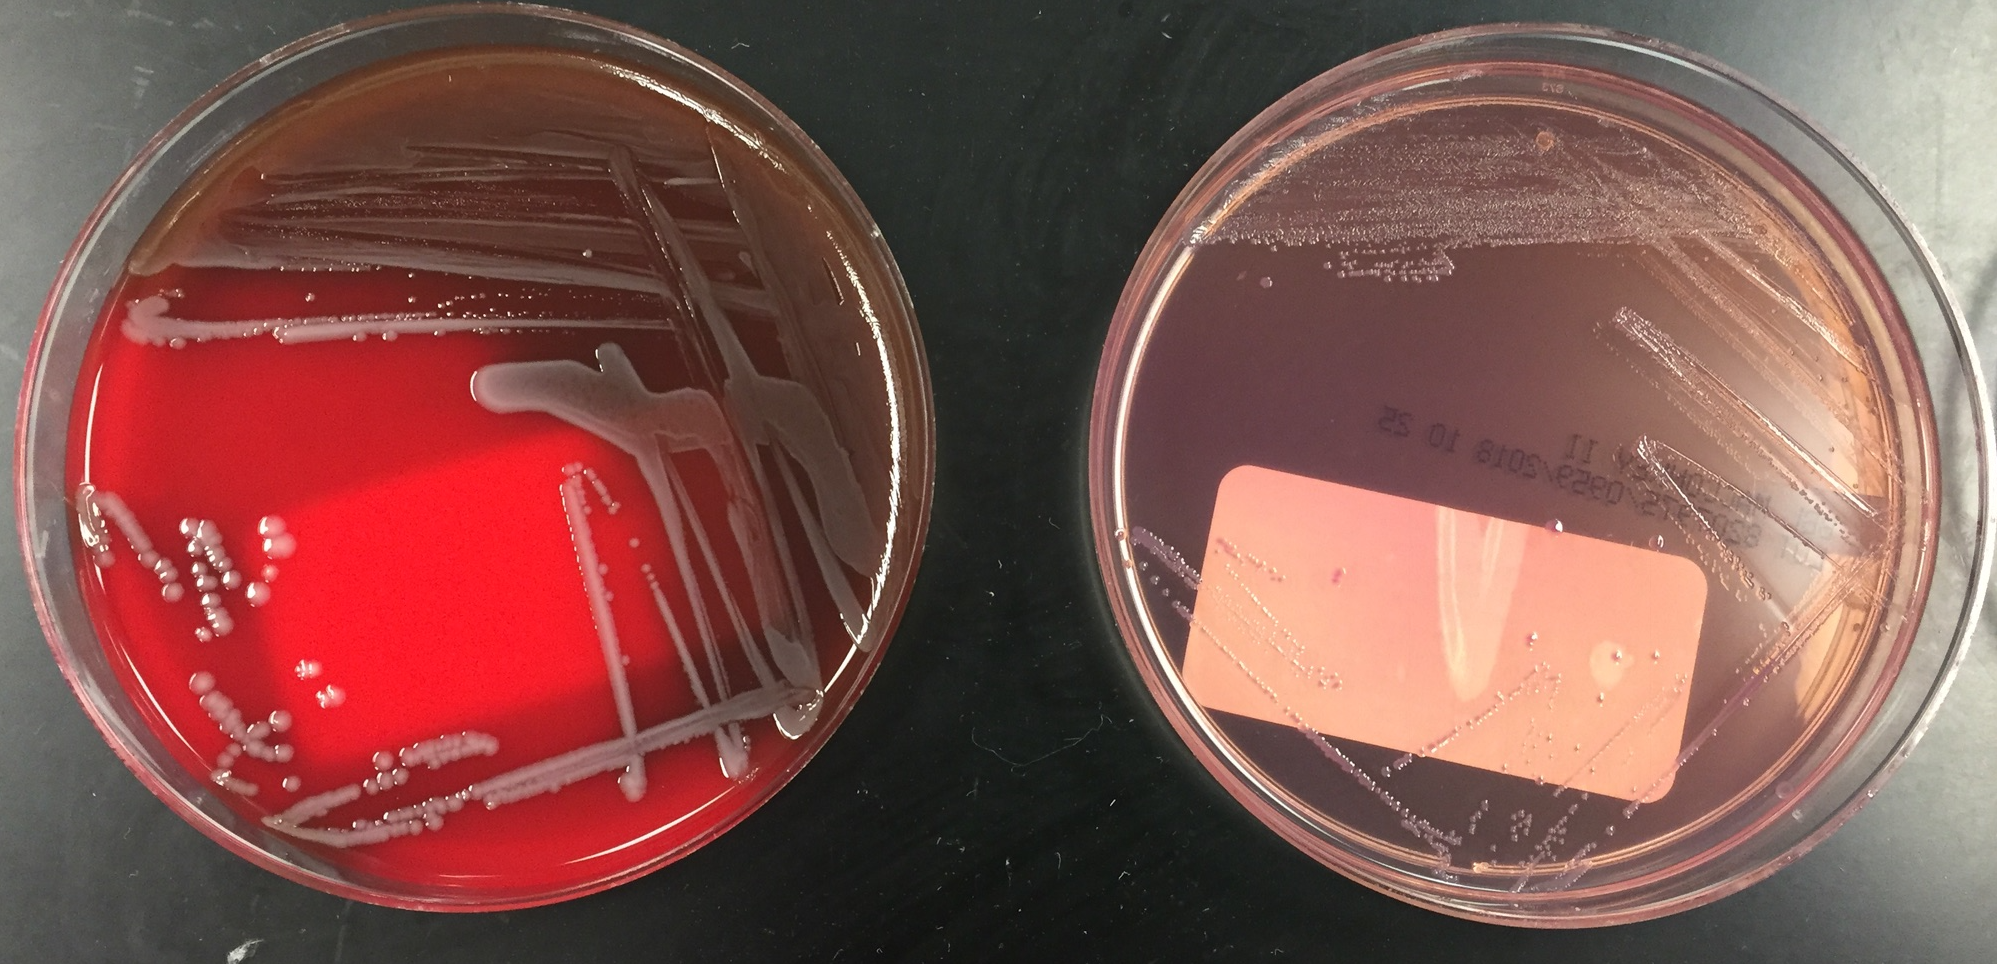

Clinical History
An 8-month-old female presented to the pediatric emergency department (ED) due to vomiting and diarrhea for the past 10 days. Per mother, the baby has had a fever and 6-8 episodes of diarrhea & 2-3 episodes of vomiting each day. On the day of admission, the mother noted the diarrhea was like mucous and contained blood and the baby was unable to tolerate anything by mouth. Past medical history was not significant and sick contacts included a sibling with a recent viral illness. In the ED, the baby had a fever of 103.1°F and was tachycardic. On physical exam, the baby was weak & lethargic with dry mucous membranes and a capillary refill of 2-3 seconds. Mom noted the baby did not produce tears when she cried and had decreased urinary output for the past 24 hours, consistent with dehydration. Initial labs revealed an elevated white count of 20.0 TH/cm2 and a C-reactive protein of 6.60 mg/dL, suggestive of an infectious process. Blood, urine, and stool cultures were sent to the microbiology laboratory and the baby was received IV fluids and ceftriaxone.
Laboratory Identification
Blood culture signaled positive after 36 hours of incubation on the automated instrument and revealed gram negative rods.

MALDI-TOF mass spectrometry identified the isolate as Yersinia enterocolitica. The urinalysis was positive and the urine culture grew >100,000 CFU/ml of Escherichia coli. Stool culture was negative for Salmonella, Shigella, E. coli O157:H7, Aeromonas, and Plesiomonas. Antigens for Shiga toxin and Campylobacter jejuni were both negative. Stool culture for Y. enterocolitica was not ordered. A multiplex PCR panel for gastrointestinal pathogens also identified Y. enterocolitica.
Discussion
Yersinia enterocolitica is a member of the Enterobactericeae family and when transferred via the fecal oral route, can cause gastroenteritis, terminal ileitis, and mesenteric lymphadenitis, particularly in young children, the elderly, and immunocompromised patients, who consume raw or undercooked pork, chitterlings, or drink unpasteurized milk products. Because Y. enterocolitica can survive and multiple at refrigerated temperatures, prepackaged lunchmeats and packed red blood cells can be common sources for infection as well. Rarely, septicemia can result from migration of the organisms into the lymph nodes and then the blood.
Stool, blood, and lymph node cultures are often submitted to the microbiology laboratory for the detection of Y. enterocolitica. The organism is a gram-negative rod that can grow well on routine media such as sheep blood, chocolate, and MacConkey agars at 22°C and 35°C in ambient air. When there is a clinical concern for gastroenteritis caused by Y. enterocolitica, a selective media such as cefsulodin-Irgasan-novobiocin (CIN) agar should be added to the stool culture to enhance isolation. Y. enterocolitica grows as “bull’s eye” colonies with a pink center and surrounding clear to white border on CIN agar.
The organism ferments glucose & sucrose, is positive for catalase & urease, and is oxidase negative. Y. enterocolitica is able to be identified by manual and automated biochemical systems, such as API 20E and Vitek as well as MALDI-TOF mass spectrometry. Culture independent multiplex PCR panels for the diagnosis of gastrointestinal syndromes are gaining popularity due to sensitivity & improved turnaround times; however, reimbursement and the necessity for the isolated organism for susceptibility testing and typing the in the case of outbreak investigations continue to be items of concern.
The majority of cases of Y. enterocolitica gastroenteritis do not require antimicrobial treatment. In the case of severe disease and those that are immunocompromised or with systemic disease should receive treatment with a fluorquinolone or trimethoprim sulfamethoxazole. While Y. enterocolitica produces beta lactamases, it is still uniformly susceptible to extended spectrum cephalosporins as well.
In the case of our patient, she received 8 days of ceftriaxone and was transitioned to oral trimethoprim sulfamethoxazole and discharged home to finish the 21-day course of antibiotics due to bacteremia from Y. enterocolitica. Mother was counseled to fully cook pork products before feeding to the baby.

-Lisa Stempak, MD, is an Assistant Professor of Pathology at the University of Mississippi Medical Center in Jackson, MS. She is certified by the American Board of Pathology in Anatomic and Clinical Pathology as well as Medical Microbiology. She is the Director of Clinical Pathology as well as the Microbiology and Serology Laboratories. Her interests include infectious disease histology, process and quality improvement, and resident education.